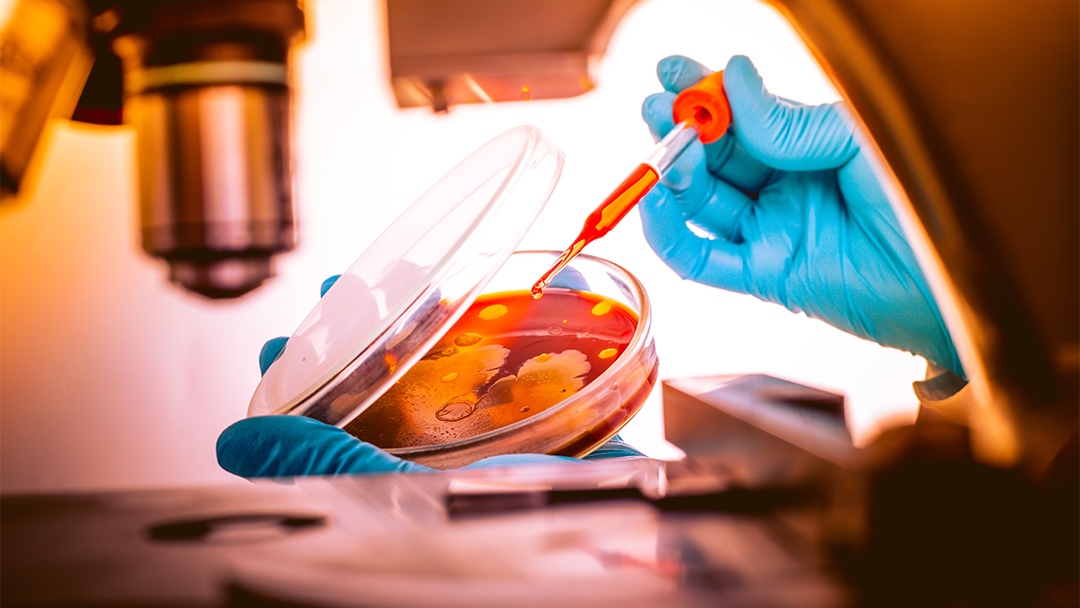
Institutional Biosafety Committee

![[FA] SIT One SITizen Alumni Initiative_Web banner_1244px x 688px.jpg](/openhouse2025/sit-teaching-and-learning-academy/centre-professional-communication/sit-teaching-and-learning-academy/openhouse/directory/openhouse/directory/openhouse/centre-professional-communication/directory/sites/default/files/2024-12/%5BFA%5D%20%20SIT%20One%20SITizen%20Alumni%20Initiative_Web%20banner_1244px%20x%20688px.jpg)
Institutional Biosafety Committee
The primary role of the Institutional Biosafety Committee (IBC) is to assess and review the use of biological materials for activities conducted by the university.
IBC supports the university to comply with legislation and guidelines, including the Biological Agents and Toxins Act (BATA) and the Singapore Biosafety Guidelines for Research on Genetically Modified Organisms (GMOs).
The biological materials or biological work activities that require review and assessment by the IBC includes:
- Activities involving animals
- Activities involving humans e.g. for clinical studies
- Activities involving insect/rodent vectors or their materials
- Biological agents and toxins listed in BATA schedules
- Inactivation of biological agents in BATA schedules
- Materials of animal origin e.g. tissue and animal cell lines
- Manipulation of genomic composition of all biological entities (cells, organisms, microorganisms, prions, viroids or viruses), i.e. GMOs
- Materials of human origin e.g. blood, urine, stem cells, tissue, human cell lines
- Materials of plant origin
- Release of agriculture GMOs
- Veterinary biologics
Get in Touch
To find out more about IBC, send us an email and we will get back to you as soon as we can.














